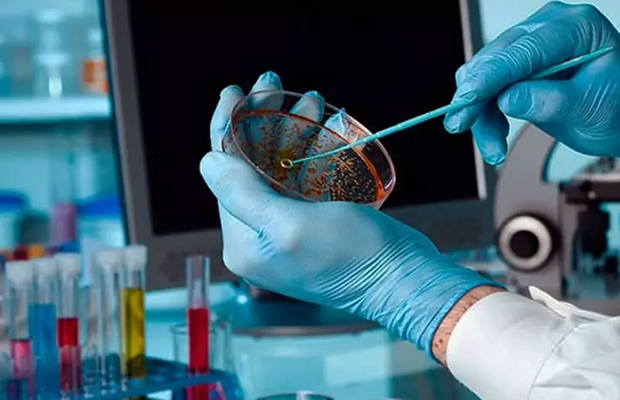

Este jueves, el decano de la Facultad de Farmacia de la Universidad Central de Venezuela (UCV), Michael Mijares, informó que junto al Ministerio del Poder Popular para Ciencia y Tecnología (Mincyt) adelantan un proyecto de investigación que tiene como objetivo desarrollar fármacos contra el cáncer.
En entrevista en el programa “Al Aire”, que transmite Venezolana de Televisión (VTV), explicó que la investigación se basa en el desarrollo de nuevas moléculas con potencial terapéutico a través de productos naturales y síntesis orgánicas, con miras a crear fármacos completamente diseñados y producidos en Venezuela.
“El objetivo principal es que en nuestro país podamos desarrollar los fármacos desde el principio y hasta el final, no solamente en la parte de investigación», apuntó al tiempo que destacó que en el proyecto participan un aproximado de 17 profesionales venezolanos.
Asimismo, detalló que la iniciativa cuenta con dos años de ejecución y recientemente se presentaron los primeros resultados en las áreas de investigación de la Facultad de Farmacia. “Los resultados son prometedores y la idea es seguir avanzando en este proceso”, agregó el decano.
Alianzas estratégicas y modernización académica
El decano también señaló que la Facultad de Farmacia mantiene alianzas con diversos organismos del sector público, privado y a nivel internacional con el propósito de actualizar el pensum académico y fortalecer las líneas de investigación.
“Nos estamos actualizando a las pautas a nivel internacional a través del Vicerrectorado Académico y nuestra Comisión Curricular, estamos actualizando nuestro pensum y acreditándonos a nivel internacional. Este proceso inició el año pasado y vamos muy avanzado», acotó.
En ese sentido, expresó que la meta es posicionar a la Facultad de Farmacia no solo como la principal del país, sino como una referencia en Latinoamérica y a nivel mundial. Para ello, se han establecido convenios y se han recibido recursos importantes destinados a la modernización de la investigación, dijo.
En el ámbito industrial, afirmó que también se han firmado acuerdos con empresas privadas para facilitar la inserción laboral de los estudiantes y acercarlos al entorno profesional.
Actualmente, el sector farmacéutico cuenta con siete menciones académicas en áreas como: tecnología industrial, tecnología de los alimentos, tecnología cosmética, farmacia hospitalaria y comunitaria, así como el área de control de calidad del medicamento, microbiología aplicada, entre otros. Además, se prevé incorporar próximamente la mención en Biotecnología.
Finalmente, Mijares anunció que al menos 350 nuevos estudiantes se han inscrito en la facultad para iniciar sus clases en el mes de octubre. “La facultad de farmacia tiene 440 estudiantes y con estos 350 estamos duplicando el monto de estudiantes que tiene la facultad”, puntualizó.
Con información de VTV